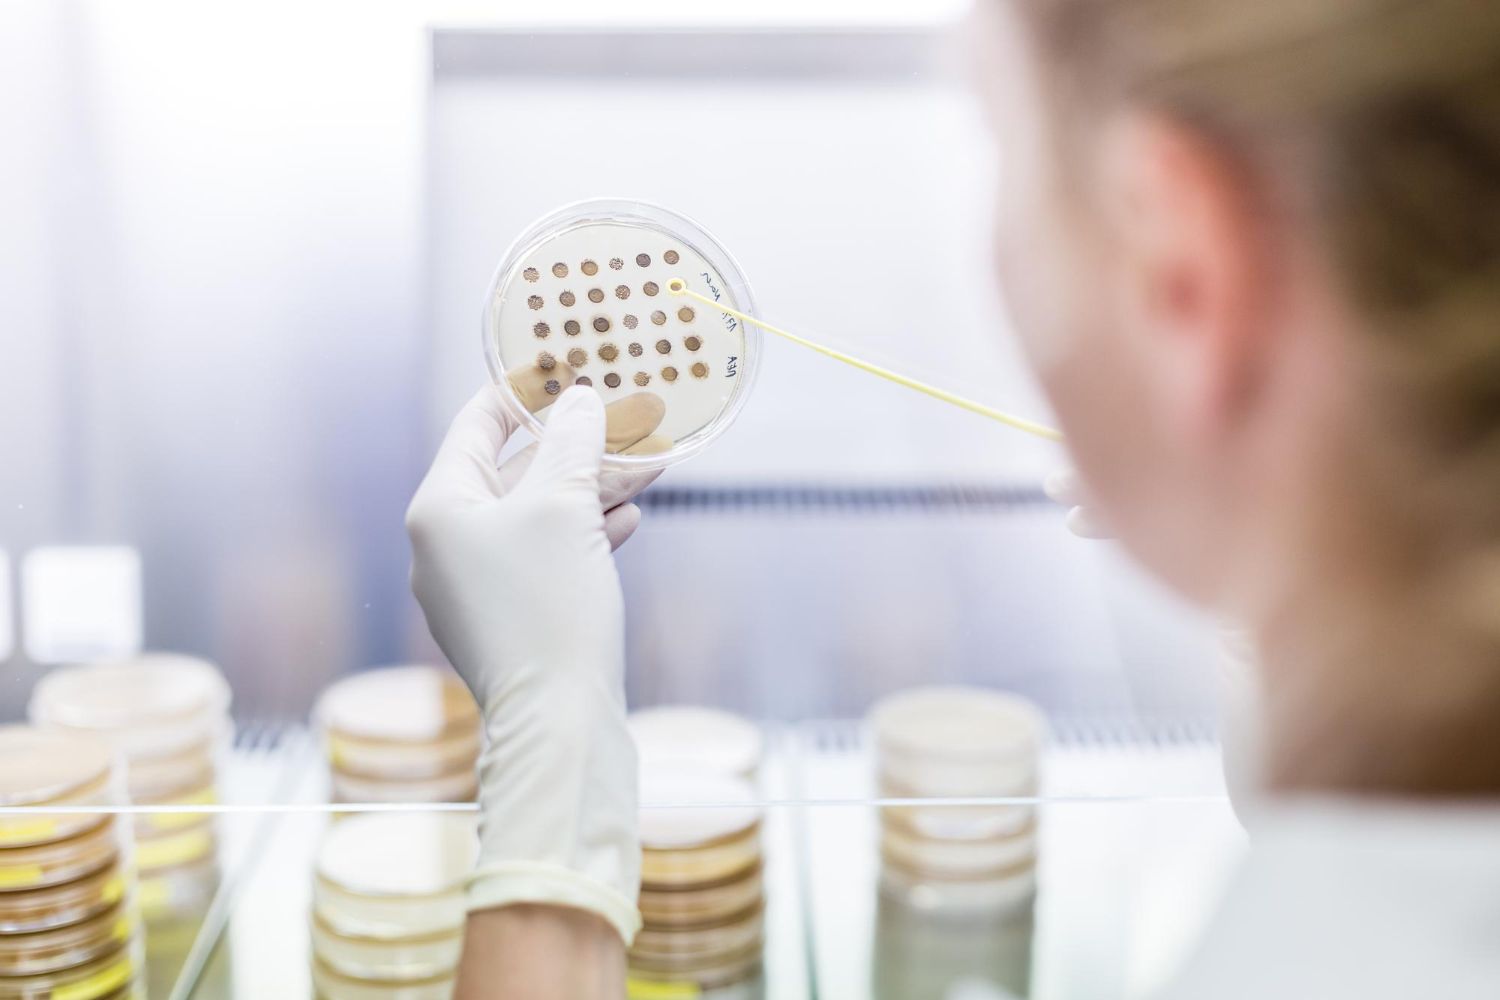
próbki żywności w laboratorium

Glifosat w maku, pestycydy w skórce pomarańczowej – nowy test Fundacji Pro-Test ujawnia, co naprawdę trafia do świątecznych ciast
W jednej próbce maku wykryto glifosat, a w czterech na pięć skórek pomarańczowych – pozostałości pestycydów – to wyniki testu 17 produktów przeprowadzonego przez Fundację Pro-Test. Badacze sprawdzili, co kryje się w składnikach, które Polacy masowo kupują przed świętami.
[Warszawa, 12.12.2025] Badania 12 próbek maku i pięciu próbek skórki pomarańczowej kupionych w największych sieciach handlowych przeprowadził na zlecenie Fundacji Pro-Test Zakład Badania Bezpieczeństwa Żywności Instytutu Ogrodnictwa – Państwowego Instytutu Badawczego w Skierniewicach.
Wyniki testu mogą być ważną wskazówką dla konsumentów, szczególnie teraz – w okresie, kiedy makowce i kutia trafiają na stoły milionów Polaków.
Mak: 11 produktów bez glifosatu, jeden – z pozostałościami
W 11 na 12 przebadanych maków nie wykryto glifosatu. Wyjątek stanowił Mak niebieski Bakalland, w którym stwierdzono 0,048 mg/kg. Jest to poziom zgodny z obowiązującymi normami, ale kluczowe pytanie brzmi: skąd ta substancja się w nim wzięła?
Glifosat może bowiem pochodzić z legalnego zwalczania chwastów, ale też z nielegalnej desykacji (chemicznego osuszania makówek przed zbiorem przy użyciu glifosatu). Wyniku nie da się jednoznacznie zinterpretować bez informacji o sposobie prowadzenia upraw.
– Dobra wiadomość dla konsumentów jest taka, że większość maków na rynku jest wolna od pozostałości glifosatu. Ale ważne jest, aby konsumenci mieli dostęp do rzetelnych danych i mogli wybierać produkty świadomie – podkreśla Piotr Koluch, prezes Fundacji Pro-Test.

Skórka pomarańczowa: nawet siedem pestycydów w jednym produkcie
Większe zastrzeżenia budzi skórka pomarańczowa, często dodawana do makowców, serników czy pierników. Wyniki testu wykazały obecność nawet siedmiu różnych pestycydów w jednym produkcie. Chodzi o skórki pomarańczowe Helio.
Niewiele mniej szkodliwych substancji wykryto w skórce kandyzowanej Bakalland – sześć pestycydów. Z kolei w skórce pomarańczy Belbake, marki własnej Lidla, znajdowało się pięć różnych pestycydów, a w skórce Kotanyi – dwa. Jedyna próbka w teście całkowicie wolna od pozostałości pestycydów to skórka marki Natürlich Gold Pack.
Trzeba tu zaznaczyć, że nie istnieją normy zawartości pestycydów dla takiego produktu, jak skórka pomarańczowa, dlatego nie ma odniesienia, które pozwalałoby stwierdzić, czy wykryte poziomy szkodliwych substancji są wysokie czy nie.
– Dlatego zawsze, kiedy mamy wybór, lepiej kupować te produkty, w których pestycydów jest jak najmniej, a najlepiej wcale – radzi Piotr Koluch.
Jakie pestycydy wykryto w skórce pomarańczowej?
Wśród wykrytych pestycydów szczególną uwagę zwraca chloropiryfos. Jest to substancja, której stosowanie w UE zostało zakazane ze względu na możliwy negatywny wpływ na rozwój układu nerwowego. W teście stwierdzono jego obecność w skórkach firmy Helio.
Najważniejsze ustalenia testu
- 11 z 12 produktów zawierających mak – bez glifosatu
- 1 produkt (Mak niebieski Bakalland) z glifosatem, ale w granicach normy
- 4 na 5 skórek pomarańczowych zawierało pozostałości pestycydów – od 2 do 7 substancji
- 1 skórka (Natürlich Gold Pack) – całkowicie wolna od pestycydów
- W badanych skórkach Helio wykryto chloropiryfos, którgo stosowanie w UE zostało zakazane ze względu na możliwy negatywny wpływ na układ nerwowy
Pełne wyniki testu maku i skórek pomarańczowych są dostępne na stronie Fundacji Pro-Test: www.pro-test.pl

